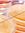
Mohamed...

Brahim KHATTARA
https://www.goodreads.com/khattibra
Algerian Bookworms
— 772 members
— last activity Nov 15, 2025 09:11AM
" A mind needs Books as a Sword needs A Whetstone" _ George R.R. Martin Welcome dear fellow Algerians (& many more!), This group was created for th ...more
ماذا تقرأ هذه الأيام؟
— 9562 members
— last activity Feb 10, 2026 10:01PM
مجموعة تهدف لتجمع القراء، لتبادل كل ما هو نافع ومفيد حول الكتب والكتاب، وهى محاكاة لمجموعة موجودة على موقع الفيسبوك، وتحمل نفس العنوان
Arabic Books
— 21181 members
— last activity Feb 28, 2026 10:51AM
بسم الله وبعد: نظرًا لأن الكتب العربية في الوقت الحالي تضاف يدويًا من بعض الأخوة والأخوات شاكرين لهم جهودهم،في القراءة والإضافة،آمل أن تكون هذه المجمو ...more
KHATTARA’s 2025 Year in Books
Take a look at KHATTARA’s Year in Books, including some fun facts about their reading.
More friends…
Favorite Genres
Polls voted on by KHATTARA
Lists liked by KHATTARA